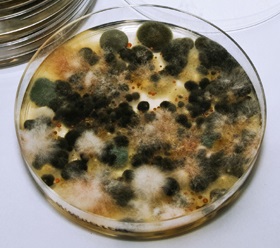
A contaminated petri dish. Various species of fungi has grown in this petri dish.

Sterilization refers to the removal of all microorganisms in a material or on an object. Sterilization ensure that even fungal spores or highly resistant bacterial endospores are killed.
Bioreactors can be sterilized with or without the medium. Bioreactors are normally sterilized by heating the jacket or coil of the bioreactor using steam in the vessel. For sterilization, steam pressure inside the vessel is 15 psi and held for 20 min. After sterilization complete, it is important to maintain positive pressure inside the vessel; otherwise, a vacuum may develop and unsterile air be drawn into the vessel.
Aseptic technique used in material transfer from the bottle. The neck of the bottle is always heated by Bunsen burner flame
When using a bioreactor, working with pure culture is always desirable. Due to the ubiquity of microorganisms, unwanted organisms known as contaminants can contaminate and make the fermentation unsuccessful. An aseptic method, which prevents the introduction of unwanted organisms into a workspace, must be applied during fermentation.
Key to work sterile is as follows:
Autoclave tape. Before autoclave; white stripe, After autoclave: black stripe
媒介及其容器必须消毒autoclaving before use to avoid contamination. The autoclave utilizes high-pressure saturated steam at 121o C for 15 to 20 minutes to kill the microorganisms on the medium and its container. To ensure that the autoclave procedure has been conducted, an autoclave tape is labeled on the bottle that contains the medium. The autoclave tape has a white stripe which will turn black if subjected to high-temperature steam. Therefore, we can identify whether a bottle of medium has been autoclaved/sterilized or not by looking at the stripe color of the autoclave tape.
Aseptic inoculum transfer: (a) Turn on the Bunsen burner.
(b) Heat the media bottle opening.
(c) Take media using the pipette, and add to a test tube.
(d) Reheat the media bottle opening.
(e) Close the media bottle.
(f) Sterilize the wire loop with Bunsen burner flame (A sterile pipette tip can also be used instead of a wire loop, and it does not need to be heated.)
(g) Take the culture with the wire loop and add to the test tube.
To calculate how much inoculum is required to be added to the fermenter, one can use the formula below: V1is the volume taken from the inoculum, C1is the concentration in the inoculum, V2is the final volume in the fermenter and C2is the concentration wanted in the fermenter.
\
Culture used to inoculate (inoculum) for fermentation meet the following criteria:
Before the culture can be used as inoculum for a large scale fermentation, it must go through several preparation steps:
Culture that has satisfied all criteria for a good inoculum must be transferred to shake flasks for culture activation. Before it can be used in a production fermenter, the activated inoculum must be gradually upscaled in prefermenters. After all steps are done without contamination, the inoculum is ready to be used in a production fermenter.